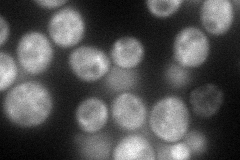
YPR105C
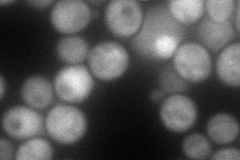
YPR105C
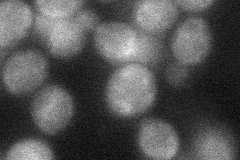
YPR105C
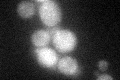
YPR105C
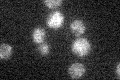
YPR105C

View description
Essential component of the conserved oligomeric Golgi complex (Cog1p through Cog8p), a cytosolic tethering complex that functions in protein trafficking to mediate fusion of transport vesicles to Golgi compartments
Localization:
Intensity:
Fold change:
Significance:
-
C’ GFP library in SD

cytosol20.71 -
N' NOP1pr-GFP in SD
cytosol,punctate84.7317 -
N' TEF2pr-mCherry in SD
cytosol105.694 -
N' NATIVEpr-GFP in SD

below threshold18.0284 -
N' TEF2pr-VC and Cyto-VN in SD
cytosol34.6209 -
C’ GFP library in SD+DTT
cytosol15.740.75No -
C’ GFP library in SD+H2O2

cytosol20.841No -
C’ GFP library in Starvation Media
cytosol17.520.84No -
C’ GFP library on the background of Pup2-DaMP

cytosol -
C’ GFP library on the background of CCT mutant

cytosol19.50110.941292No
